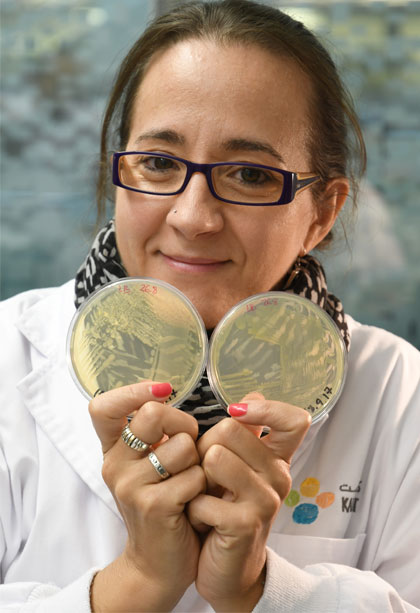

Post-doctoral Fellow
Cristina Andrés-Barrao
Born and raised in Zaragoza, Spain, I was since my early childhood fascinated
by sciences, with the biggest interest in biological sciences. I obtained a Bachelor Degree in
Chemistry at the University of Zaragoza, what I completed with a Master Degree in Organic Chemistry
and another in Biochemistry.
To continue my academic formation and acquire the international experience that was avid, I was
awarded with a European Community Action Scheme for the Mobility of University Students (Erasmus
Mundus) Scholarship that brought me to Geneva, Switzerland. There, I join the group of Dr. Francois
Barja, at the department of Plant Biology at the University of Geneva (UNIGE), to work with Dr. Marta
Cotado (PhD student at that time) in a project related with the study of cytoskeletal proteins in the
fungus Neurospora crassa. Already experiencing an increasing interest in microbiology, I decided to
accept an offer of Dr. Barja and start a PhD on a relatively new research line of the group, acetic
acid bacteria (AAB), studying the characterization of bacterial strains involved in acetic acid
fermentation, their identification and taxonomy, and the resistance of these strains to high
percentages of acetic acid. I applied molecular biology techniques and basic comparative genomics and
had the pleasure to attend international conferences in Switzerland and Japan (Best Poster Award at
the The 2nd International Conference on Acetic Acid Bacteria in 2008), and successfully defended my
PhD thesis in September 2012.
After a short period as Postdoc in Dr. Barja group, I moved to Tokyo, Japan, thanks to a Postdoctoral
fellowship awarded by the Japanese Society for the Promotion of Science (JSPS), to join the group of
Prof. Akiko Okamoto-Kainuma, at the Tokyo University of Agriculture (NODAI). There, I continued my
research on AAB working on a project that was mainly focused on the use of transcriptomics (RNA-Seq)
to study the metabolism modifications of AAB during in vitro acetic acid fermentation mimicking the
industrial production of vinegar.
At this stage, I had a renewed interest in extremophile microorganisms, and I was also keen to move
forward to new fields, so I decided to accept an offer of Dr. Maged M. Saad, a previous colleague at
the University in Geneva, to re-direct my research towards the study of plant growth-promoting
bacteria (PGPB). In 2015 I joined the group of Prof. Heribert Hirt, at the King Abdullah University of
Science and Technology (KAUST), to work on a research project (Darwin21, http://www.darwin21.net) that
aims to isolate and thoroughly characterize PGPB from desert endogenous plants, with the final goal to
apply PGPB as alternative biofertilizer to improve agriculture in desert and arid regions.



 orcid.org/0000-0002-5655-8674
orcid.org/0000-0002-5655-8674